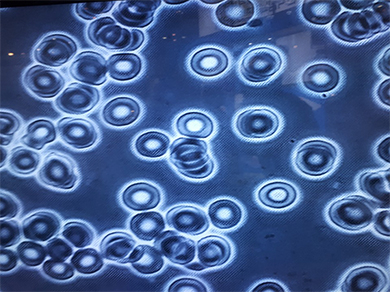

본문 영역
ကိုယ္ခႏၶာႏွင့္ သံလိုက္စက္ကြင္း
-
The Four Elemnts of Health
-
 FOOD
FOOD -
 WATER
WATER -
 SUNLIGHT
SUNLIGHT -
 OXYGEN
OXYGEN
-
-
The Fifth Elements ofPEMF
က်န္းမာေရး၏ အေျခခံလိုအပ္ခ်က္ ၄ ခ်က္သည္ အစားအစာ၊ ေရ၊ ေနေရာင္ျခည္ႏွင့္ ေအာက္စီဂ်င္တို႔ ျဖစ္ပါသည္။ ထပ္မံ၍ ၅ ႀကိမ္ေျမာက္ အေျခခံလိုအပ္ခ်က္သည္ PEMF ျဖစ္ပါသည္။ PEMF သည္ လူ႕ခႏၶာကိုယ္ရိွ ဆဲလ္မ်ား၏ အားသြင္းစက္ ျဖစ္ပါသည္။

သံလိုက်စက်ကွင်းကုထုံးစနစ် အဖြစ်အများဆုံးကုသမှုအကျိုးသက်ရောက်မှု
သွေးလှည့်ပတ်မှု ကောင်းမွန်စေခြင်း။
သံလိုက်စက်ကွင်းလှုံ့ဆော်ပေးသည့်ကိရိယာသည် ရစ်ပတ်လျှပ်စီးကြောင်းများကိုထုတ်ပေးပြီး ထိတွေ့မှုမရှိသောပုံစံဖြင့် နက်နဲစွာသက်ရောက်သည်။
-
 သံလိုက္စက္ကြင္းကုသမႈ မခံယူမီ ေသြးနီဥ
သံလိုက္စက္ကြင္းကုသမႈ မခံယူမီ ေသြးနီဥ -
သံလိုက္စက္ကြင္းကုသမႈ ခံယူၿပီးေနာက္ ေသြးနီဥ
သံလိုက္စက္ကြင္းကုသမႈ ခံယူၿပီးေနာက္ ေသြးနီဥ
-
 EFFECT ON CELLSPEMF က ဆဲလ္မ်ားကို ေပးေသာ အာနိသင္
EFFECT ON CELLSPEMF က ဆဲလ္မ်ားကို ေပးေသာ အာနိသင္- ဆဲလ္မ်ားအတြင္း ေသြးလည္ပတ္မႈကို ေကာင္းမြန္ေစျခင္း။
- ATP ထြက္ေပၚမႈႏႈန္း ျမွင့္တင္ေပးျခင္း
- ဆဲလ္မ်ား၏ စြမ္းအင္ အဆင့္ျမွင့္တင္ေပးျခင္း။
- ဆဲလ္မ်ားအတြင္း ေအာက္စီဂ်င္ပမာဏ မ်ားျပားလာေစျခင္း။
- ဆဲလ္မ်ားကို လ်င္ျမန္စြာ ျပန္လည္ကုသေပးႏိုင္ျခင္း။
- ဆဲလ္မ်ား အခ်င္းခ်င္း ဆက္သြယ္မႈ ေကာင္းမြန္လာေစျခင္း။
- ဆဲလ္အတြင္း သံဓာတ္ ပို႕ေဆာင္ေပးျခင္း။
-
 BIOLOGICAL EFFECTPEMF ၏ ဇီဝအာနိသင္
BIOLOGICAL EFFECTPEMF ၏ ဇီဝအာနိသင္- သွေးလှည့်ပတ်မှုကြောင့် နာကျင်မှုကို သက်သာစေသည်။
- ဆဲလ္မ်ားကို အလ်င္အျမန္ ကုသေပးႏိုင္ျခင္း။
- ဆဲလ္ႀကီးထြားမႈ လ်င္ျမန္ေစျခင္း။
- ေသြးႏွင့္ ေသြးျဖဴရည္ၾကည္ လည္ပတ္မႈ ပိုမို ေကာင္းမြန္လာျခင္း။
- ဒဏ္ရာမ်ားကို လ်င္ျမန္စြာ ေပ်ာက္ကင္းေစႏိုင္ျခင္း။
- ဆဲလ္အမွ်င္အစုအေဝး ျဖစ္ေပၚမႈ ေလ်ာ့နည္းေစျခင္း။
- ဖူးေရာင္ျခင္းႏွင့္ ေရာင္ရမ္းျခင္းကို သက္သာေစျခင္း။
- အင္ဒိုဖိုင္းေဟာ္မုန္း ထြက္ေပၚမႈႏႈန္းကို ျမွင့္တင္ေပးျခင္း။
-
 HUMAN PHYSIOLOGYCAL EFFECTPEMF ၏ ခႏၶာကိုယ္ဇီဝကမၼဆိုင္ရာ အာနိသင္
HUMAN PHYSIOLOGYCAL EFFECTPEMF ၏ ခႏၶာကိုယ္ဇီဝကမၼဆိုင္ရာ အာနိသင္- ခံရခက္ေသာ ခႏၶာကိုယ္ နာက်င္မႈကို ေလ်ာ့နည္းသက္သာေစႏိုင္ျခင္း။
- နာတာရွည္ ျပည္တည္နာ သက္သာေစႏိုင္ျခင္း။
- ေသြးလည္ပတ္မႈစြမ္းရည္ ျမင့္မားလာျခင္းျဖင့္ ကိုယ္ခံအားစနစ္ကို ဟန္ခ်က္ညီေစျခင္း။
- အရိုးႏွင့္ အေၾကာမ်ား ျပန္လည္သန္မာလာေစျခင္း။
- ၾကြက္သားမ်ား တင္းမာျခင္းႏွင့္ စိတ္ဖိစီးမႈကို ေလ်ာ့က်ေစျခင္း။
- ဆဲလ္၏ စြမ္းအင္၊ ေသြးလည္ပတ္မႈ၊ ေသြးႏွင့္ ဆဲလ္အစုအေဝးမ်ားအတြင္း အက္ဆစ္ဓာတ္ရိွမႈ၊ အိပ္စက္ျခင္း၊ ေသြးဖိအားႏွင့္ ကိုလက္စထေရာပါဝင္မႈ၊ အဟာရစုပ္ယူျခင္း၊ ဆဲလ္အဆိပ္သင့္ျခင္းႏွင့္ ဆဲလ္ ျပန္လည္ကုသမႈစြမ္းအင္မ်ားကို တိုးတက္လာေစပါသည္။
သံလိုက္စည္းခ်က္ေဆးပညာ၏ အက်ိဳးေက်းဇူးမ်ား
-
- ၁။ ေသြးေၾကာမ်ား ႀကီးမားလာေစျခင္း
- ၂။ ေသြးေၾကာ က်ယ္လာေစျခင္း။
- ၃။ ေသြးစီးဆင္းမႈ ပမာဏ မ်ားျပားလာေစျခင္း။
- ၄။ အရိုးပြေရာဂါကဲ့သို႔ အရိုးေရာဂါမ်ား လ်င္ျမန္စြာ ေပ်ာက္ကင္းေစျခင္း။
- ၅။ အဆစ္အျမစ္ေရာဂါမ်ားကို ကုသေပးႏိုင္ျခင္း။
- ၆။ အာရံုေၾကာေရာဂါကို ကုသေပ်ာက္ကင္းႏိုင္ျခင္း။
- ၇။ ျပည္တည္နာကို ကုသေပ်ာက္ကင္းေစႏိုင္ျခင္း။
- ၈။ ကင္ဆာအက်ိတ္မ်ား ေလ်ာ့နည္းေစႏိုင္ျခင္း။
- ၉။ နာက်င္ကိုက္ခဲမႈ ေဝဒနာမ်ား ေလ်ာ့နည္းေစႏိုင္ျခင္း။
- ၁၀။ စိတ္က်ေရာဂါကို သက္သာေစႏိုင္ျခင္း (TMS)။
- ၁၁။ ဆီးဝမ္းမထိန္းခ်ဳပ္ႏိုင္ျခင္းကို သက္သာေစႏိုင္ျခင္း။
- ၁၂။ ဆီးက်ိတ္ေရာဂါ (Prostatitis) ကို သက္သာေစႏိုင္ျခင္း။
- ၁၃။ ဓမၼတာလာခ်ိန္ နာက်င္မႈကို သက္သာေစႏိုင္ျခင္း။
- ၁၄။ ခႏၶာကိုယ္ အပူခ်ိန္ ျမွင့္တင္ေပးျခင္း။
본문 공유 설정